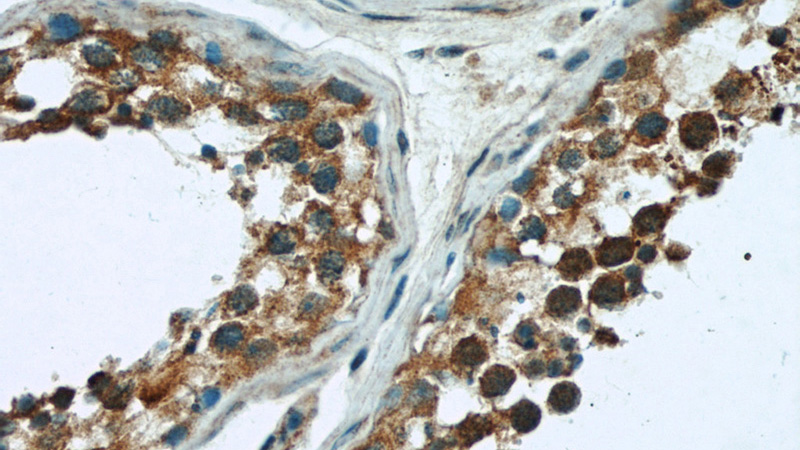
Immunohistochemical of paraffin-embedded human testis using Catalog No:114445(RAB3GAP1 antibody) at dilution of 1:100 (under 40x lens)
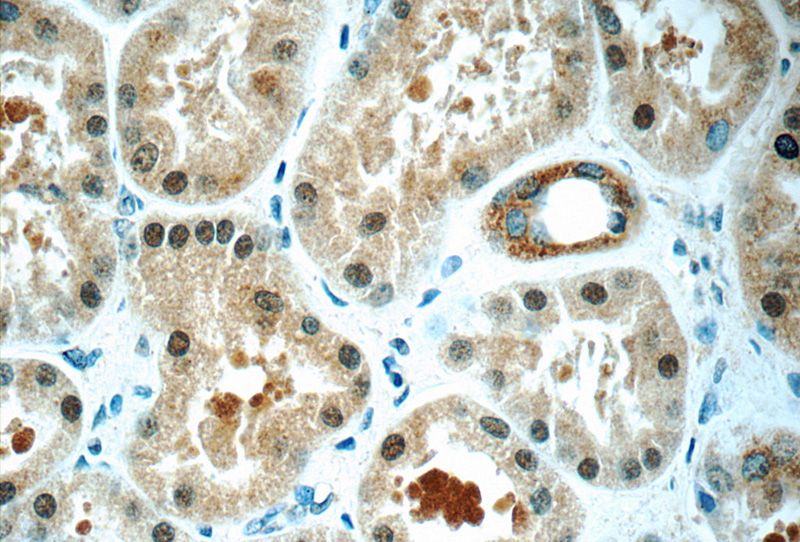
Immunohistochemistry of paraffin-embedded human kidney tissue slide using Catalog No:114445(RAB3GAP1 Antibody) at dilution of 1:50 (under 40x lens)

-
Product Name
RAB3GAP1 antibody
- Documents
-
Description
RAB3GAP1 Rabbit Polyclonal antibody. Positive IP detected in mouse kidney tissue. Positive WB detected in HEK-293 cells, HL-60 cells, human brain tissue, mouse heart tissue, mouse kidney tissue. Positive IF detected in HepG2 cells, Hela cells. Positive IHC detected in human testis tissue, human brain tissue, human kidney tissue. Observed molecular weight by Western-blot: 130 kDa
-
Tested applications
ELISA, WB, IHC, IF, IP
-
Species reactivity
Human,Mouse,Rat; other species not tested.
-
Alternative names
DKFZp434A012 antibody; KIAA0066 antibody; P130 antibody; Rab3 GAP antibody; Rab3 GAP p130 antibody; RAB3 GTPase-activating protein 1 antibody; RAB3GAP antibody; RAB3GAP1 antibody; RAB3GAP130 antibody; WARBM1 antibody
-
Isotype
Rabbit IgG
-
Preparation
This antibody was obtained by immunization of RAB3GAP1 recombinant protein (Accession Number: BC146809). Purification method: Antigen affinity purified.
-
Clonality
Polyclonal
-
Formulation
PBS with 0.02% sodium azide and 50% glycerol pH 7.3.
-
Storage instructions
Store at -20℃. DO NOT ALIQUOT
-
Applications
Recommended Dilution:
WB: 1:1000-1:10000
IP: 1:200-1:2000
IHC: 1:20-1:200
IF: 1:10-1:100
-
Validations

HEK-293 cells were subjected to SDS PAGE followed by western blot with Catalog No:114445(RAB3GAP1 antibody) at dilution of 1:500

IP Result of anti-RAB3GAP1 (IP:Catalog No:114445, 5ug; Detection:Catalog No:114445 1:500) with mouse kidney tissue lysate 6000ug.
Immunohistochemical of paraffin-embedded human testis using Catalog No:114445(RAB3GAP1 antibody) at dilution of 1:100 (under 40x lens)

Immunofluorescent analysis of HepG2 cells, using RAB3GAP1 antibody Catalog No:114445 at 1:25 dilution and Rhodamine-labeled goat anti-rabbit IgG (red). Blue pseudocolor = DAPI (fluorescent DNA dye).
Immunohistochemistry of paraffin-embedded human kidney tissue slide using Catalog No:114445(RAB3GAP1 Antibody) at dilution of 1:50 (under 40x lens)
-
Background
RAB3GAP1 (RAB3 GTPase-activating protein 1) is the catalytic subunit of the heterodimeric enzyme RAB3GAP (RAB3GTPase-activating protein), a key regulator of the RAB3 cycle, which controls calcium-mediated exocytosis of neurotransmitters and hormones. Mutations in RAB3GAP1 cause Warburg Micro syndrome (OMIM 600118) and Martsolf syndrome (OMIM 212720), phenotypically overlapping autosomal recessive conditions characterized by ocular and neurodevelopmental manifestations.
-
References
- Gerondopoulos A, Bastos RN, Yoshimura S. Rab18 and a Rab18 GEF complex are required for normal ER structure. The Journal of cell biology. 205(5):707-20. 2014.
- Baron Y, Pedrioli PG, Tyagi K. VAPB/ALS8 interacts with FFAT-like proteins including the p97 cofactor FAF1 and the ASNA1 ATPase. BMC biology. 12:39. 2014.
- Handley MT, Carpanini SM, Mali GR. Warburg Micro syndrome is caused by RAB18 deficiency or dysregulation. Open biology. 5(6):150047. 2015.
Related Products / Services
Please note: All products are "FOR RESEARCH USE ONLY AND ARE NOT INTENDED FOR DIAGNOSTIC OR THERAPEUTIC USE"
